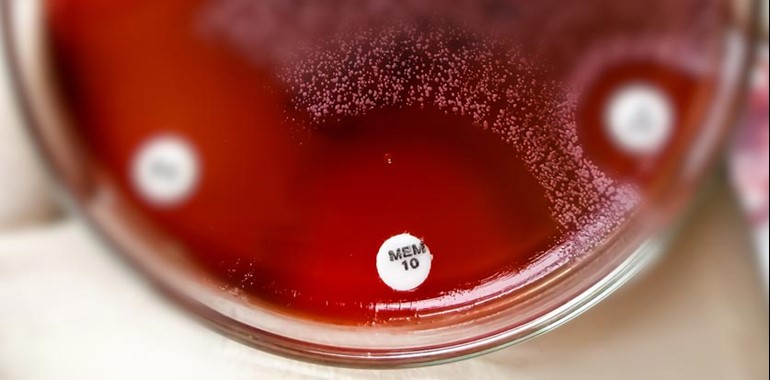

Mast continue to support the fight against AMR
The prevalence of antibiotic resistance amongst anaerobes is emerging and in recent decades several species have developed resistance to broad spectrum antibiotics such as Meropenem, Piperacillin-Tazobactam and Metronidazole.
EUCAST has recently published a new disc diffusion method for anaerobic bacteria, as other methods including MIC determination using gradient strips are expensive, and the agar dilution method is not deemed practical for routine testing. With increasing antibiotic resistance, disc diffusion to determine antimicrobial susceptibility testing (AST), is more relevant and offers a cost effective, efficient and accurate susceptibility method that is easily integrated into routine laboratories. Accordingly this has benefits to patient care, but will also provide an insight into the current prevalence and surveillance of AMR amongst anaerobic bacteria.
With only a few adaptations from the standard EUCAST method, there are QC ranges available for six QC strains using Benzylpenicillin 1µg, Piperacillin-Tazobactam 30-6µg, Meropenem 10µg, Clindamycin 2µg, Metronidazole 5µg and Vancomycin 5µg. These are all available from Mast’s Cartridge stock range of MASTDISCS® AST, available in a convenient 5 x 50 format and compatible with the MAST® DISCMASTER dispenser for smooth integration into current laboratory workflows.
For more information please use the Contact Us button at the bottom of this page.